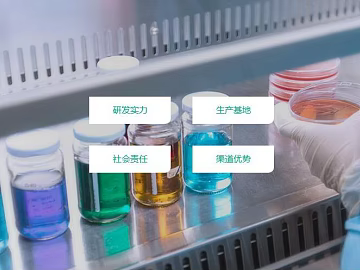
Screen material texture (ID:ffaeg90232)

dust leakage mask
Relebook has prepared many textures related to your search term
"dust leakage mask".
When searching fordust leakage mask
on Relebook, you'll discover a variety of 3D textures in different materials, sizes, and styles. Easily download and incorporate these 3Ddust leakage mask
textures into your design projects to enhance the presentation of your designs and improve design efficiency.